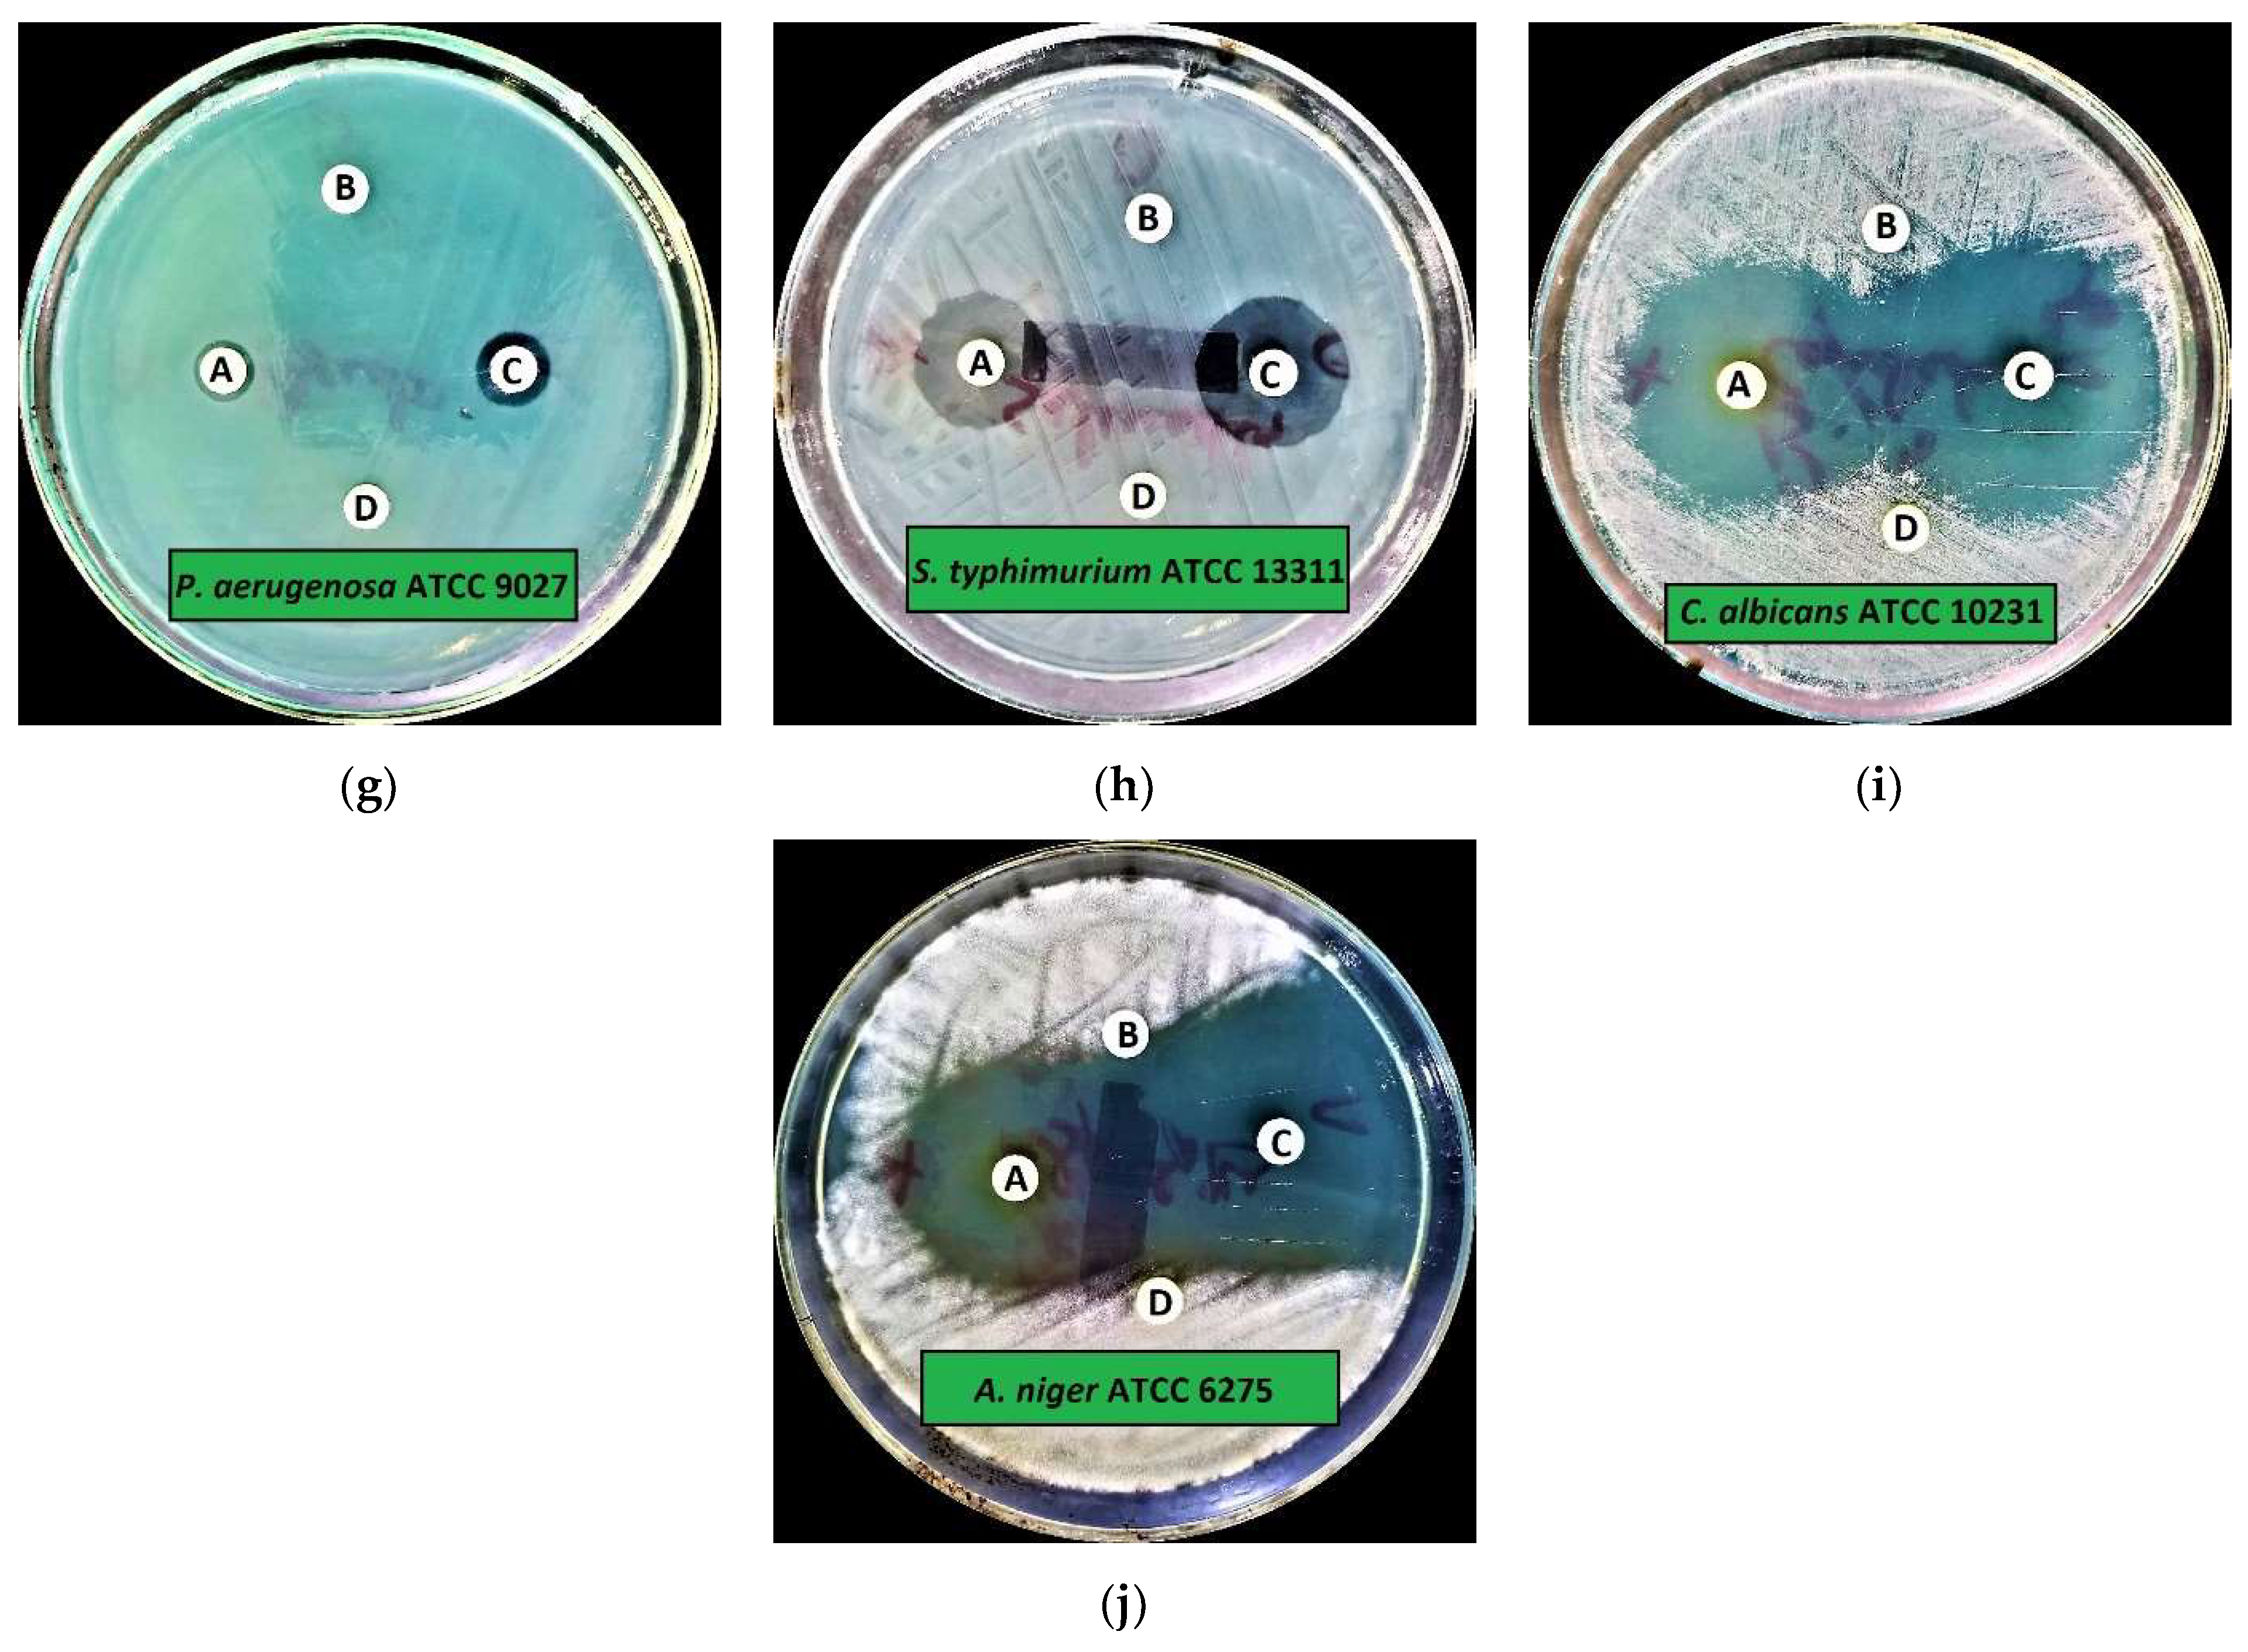

Cinnamaldehyde-Based Self-Nanoemulsion (CA-SNEDDS) Accelerates Wound Healing and Exerts Antimicrobial, Antioxidant, and Anti-Inflammatory Effects in Rats’ Skin Burn Model
Abstract
1. Introduction
2. Results and Discussion
2.1. Physicochemical Characterization of SNEDDS and CA-SNEDDS
2.1.1. Particle Size and Polydispersity Index
2.1.2. Surface Charge Analysis
2.1.3. Fourier-Transform Infrared Spectroscopy (FT-IR)-Based Computability Analysis of CA-SNEDDS
2.2. Antimicrobial Activity of CA-SNEDDS
2.2.1. Preliminary Antimicrobial Activity
2.2.2. Minimum Inhibitory Concentration (MIC), Minimum Biocidal Concentration (MBC), Minimum Biofilm Inhibitory Concentration (MBIC), and Minimum Biofilm Eradication Concentration (MBEC)
2.2.3. Statistical Analysis
2.3. In Vitro Antioxidant Activity of CA and CA-SNEDDS
2.4. Wound Healing Activity of CA-SNEDDS
2.5. Role of Oxidative/Antioxidant Markers in Skin Wound Healing
2.6. Role of Pro/Anti-Inflammatory Markers in Skin Wound Healing
3. Materials and Methods
3.1. Materials
3.2. Formulation of SNEDDS and CA-SNEDDS
3.3. Characterization of CA-SNEDDS Formulation
3.3.1. Particle Size and Polydispersity Index
3.3.2. Surface Charge Analysis
3.3.3. FT-IR Analysis
3.4. Antimicrobial Activity of CA-SNEDDS
3.4.1. Test Organisms
3.4.2. Preliminary Antimicrobial Activity
3.4.3. MIC and MBC
3.4.4. MBIC and MBEC
3.5. In Vitro Antioxidant Assay
3.6. Wound Healing Experiment
3.6.1. Animal Groups
3.6.2. Skin Burn Induction
3.6.3. Determination of Oxidants and Antioxidants
3.6.4. Determination of Inflammatory Marker in Skin Wound Tissue
3.7. Statistical Analysis
4. Conclusions
Supplementary Materials
Author Contributions
Funding
Institutional Review Board Statement
Informed Consent Statement
Data Availability Statement
Acknowledgments
Conflicts of Interest
Sample Availability
References
- Chang, W.L.; Cheng, F.C.; Wang, S.P.; Chou, S.T.; Shih, Y. Cinnamomum cassia essential oil and its major constituent cinnamaldehyde induced cell cycle arrest and apoptosis in human oral squamous cell carcinoma HSC-3 cells. Environ. Toxicol. 2017, 32, 456–468. [Google Scholar] [CrossRef]
- Lin, S.S.C.; Lu, T.M.; Chao, P.C.; Lai, Y.Y.; Tsai, H.T.; Chen, C.S.; Lee, Y.P.; Chen, S.C.; Chou, M.C.; Yang, C.C. In vivo cytokine modulatory effects of cinnamaldehyde, the major constituent of leaf essential oil from Cinnamomum osmophloeum Kaneh. Phyther. Res. 2011, 25, 1511–1518. [Google Scholar] [CrossRef] [PubMed]
- Ahmad Khan, M.S.; Chattopadhyay, D.; Ahmad, I. New Look to Phytomedicine: Advancements in Herbal Products as Novel Drug Leads; Academic Press: Piscataway, NJ, USA, 2018; ISBN 9780128146200. [Google Scholar]
- Al-Bayati, F.A.; Mohammed, M.J. Isolation, identification, and purification of cinnamaldehyde from Cinnamomum zeylanicum bark oil. An antibacterial study. Pharm. Biol. 2009, 47, 61–66. [Google Scholar] [CrossRef]
- Youn, H.S.; Lee, J.K.; Choi, Y.J.; Saitoh, S.I.; Miyake, K.; Hwang, D.H.; Lee, J.Y. Cinnamaldehyde suppresses toll-like receptor 4 activation mediated through the inhibition of receptor oligomerization. Biochem. Pharmacol. 2008, 75, 494–502. [Google Scholar] [CrossRef]
- Reddy, A.M.; Seo, J.H.; Ryu, S.Y.; Kim, Y.S.; Kim, Y.S.; Min, K.R.; Kim, Y. Cinnamaldehyde and 2-methoxycinnamaldehyde as NF-κB inhibitors from Cinnamomum cassia. Planta Med. 2004, 70, 823–827. [Google Scholar] [CrossRef]
- Mateen, S.; Rehman, M.T.; Shahzad, S.; Naeem, S.S.; Faizy, A.F.; Khan, A.Q.; Khan, M.S.; Husain, F.M.; Moin, S. Anti-oxidant and anti-inflammatory effects of cinnamaldehyde and eugenol on mononuclear cells of rheumatoid arthritis patients. Eur. J. Pharmacol. 2019, 852, 14–24. [Google Scholar] [CrossRef]
- Meng, M.; Geng, S.; Du, Z.; Yao, J.; Zheng, Y.; Li, Z.; Zhang, Z.; Li, J.; Duan, Y.; Du, G. Berberine and cinnamaldehyde together prevent lung carcinogenesis. Oncotarget 2017, 8, 76385–76397. [Google Scholar] [CrossRef]
- Karumathil, D.P.; Surendran-Nair, M.; Venkitanarayanan, K. Efficacy of Trans-cinnamaldehyde and Eugenol in Reducing Acinetobacter baumannii Adhesion to and Invasion of Human Keratinocytes and Controlling Wound Infection In Vitro. Phyther. Res. 2016, 30, 2053–2059. [Google Scholar] [CrossRef]
- Friedman, M. Chemistry, Antimicrobial Mechanisms, and Antibiotic Activities of Cinnamaldehyde against Pathogenic Bacteria in Animal Feeds and Human Foods. J. Agric. Food Chem. 2017, 65, 10406–10423. [Google Scholar] [CrossRef]
- Mishra, P.; Gupta, P.; Pruthi, V. Cinnamaldehyde incorporated gellan/PVA electrospun nanofibers for eradicating Candida biofilm. Mater. Sci. Eng. C 2021, 119, 111450. [Google Scholar] [CrossRef]
- Yuan, X.; Han, L.; Fu, P.; Zeng, H.; Lv, C.; Chang, W.; Runyon, R.S.; Ishii, M.; Han, L.; Liu, K.; et al. Cinnamaldehyde accelerates wound healing by promoting angiogenesis via up-regulation of PI3K and MAPK signaling pathways. Lab. Investig. 2018, 98, 783–793. [Google Scholar] [CrossRef] [PubMed]
- Kucinska-Lipka, J.; Gubanska, I.; Lewandowska, A.; Terebieniec, A.; Przybytek, A.; Cieśliński, H. Antibacterial polyurethanes, modified with cinnamaldehyde, as potential materials for fabrication of wound dressings. Polym. Bull. 2019, 76, 2725–2742. [Google Scholar] [CrossRef]
- Kenawy, E.; Omer, A.M.; Tamer, T.M.; Elmeligy, M.A.; Eldin, M.S.M. Fabrication of biodegradable gelatin/chitosan/cinnamaldehyde crosslinked membranes for antibacterial wound dressing applications. Int. J. Biol. Macromol. 2019, 139, 440–448. [Google Scholar] [CrossRef] [PubMed]
- Liu, Y.; Liang, X.; Zhang, R.; Lan, W.; Qin, W. Fabrication of electrospun polylactic acid/Cinnamaldehyde/β-cyclodextrin fibers as an antimicrobialwound dressing. Polymers 2017, 9, 464. [Google Scholar] [CrossRef]
- Cheirmadurai, K.; Thanikaivelan, P.; Murali, R. Highly biocompatible collagen-Delonix regia seed polysaccharide hybrid scaffolds for antimicrobial wound dressing. Carbohydr. Polym. 2016, 137, 584–593. [Google Scholar] [CrossRef]
- Ferro, T.A.F.; Souza, E.B.; Suarez, M.A.M.; Rodrigues, J.F.S.; Pereira, D.M.S.; Mendes, S.J.F.; Gonzaga, L.F.; Machado, M.C.A.M.; Bomfim, M.R.Q.; Calixto, J.B.; et al. Topical application of cinnamaldehyde promotes faster healing of skin wounds infected with pseudomonas aeruginosa. Molecules 2019, 24, 1627. [Google Scholar] [CrossRef]
- Pembrey, M.S. The Functions of the Skin. Br. J. Dermatol. 1910, 22, 323–329. [Google Scholar] [CrossRef][Green Version]
- Hampton, S. Bacteria and wound healing. J. Commun. Nurs. 2007, 21, 32–40. [Google Scholar]
- Gibran, N.S.; Boyce, S.; Greenhalgh, D.G. Cutaneous wound healing. J. Burn Care Res. Mass Med. Soc. 2007, 28, 577–579. [Google Scholar] [CrossRef]
- Bolton, L.; McNees, P.; van Rijswijk, L.; de Leon, J.; Lyder, C.; Kobza, L.; Edman, K.; Scheurich, A.; Shannon, R.; Toth, M. Wound-healing outcomes using standardized assessment and care in clinical practice. J. Wound. Ostomy Cont. Nurs. 2004, 31, 65–71. [Google Scholar] [CrossRef]
- Thompson, P.; Langemo, D.; Anderson, J.; Hanson, D.; Hunter, S. Skin care protocols for pressure ulcers and incontinence in long-term care: A quasi-experimental study. Adv. Skin Wound Care 2005, 18, 422–429. [Google Scholar] [CrossRef] [PubMed]
- Kumar, B.; Vijayakumar, M.; Govindarajan, R.; Pushpangadan, P. Ethnopharmacological approaches to wound healing-Exploring medicinal plants of India. J. Ethnopharmacol. 2007, 114, 103–113. [Google Scholar] [CrossRef] [PubMed]
- Aliabadi, A.; Valadaan, V. Comparison between the effect of silymarin and silver sulfadiazine on burned wound healing in rats. Bulg. J. Vet. Med. 2016, 19, 224–232. [Google Scholar] [CrossRef]
- Nasiri, E.; Hosseinimehr, S.J.; Akbari, J.; Azadbakht, M.; Azizi, S. The Effects of Punica granatum Flower Extract on Skin Injuries Induced by Burn in Rats. Adv. Pharmacol. Sci. 2017, 2017, 3059745. [Google Scholar] [CrossRef] [PubMed]
- Mitsunaga Junior, J.K.; Gragnani, A.; Ramos, M.L.C.; Ferreira, L.M. Rat an experimental model for burns: A systematic review. Acta Cir. Bras. 2012, 27, 417–423. [Google Scholar] [CrossRef]
- Papadakis, M.A.; McPhee, S.J.; Rabow, M.C. Medical Diagnosis & Treatment; Mc Graw Hill: San Francisco, CA, USA, 2019. [Google Scholar]
- Devi, M.V.; Poornima, V.; Sivagnanam, U.T. Wound healing in second-degree burns in rats treated with silver sulfadiazine: A systematic review and meta-analysis. J. Wound Care 2022, 31, S24–S30. [Google Scholar] [CrossRef]
- Dwivedi, D.; Dwivedi, M.; Malviya, S.; Singh, V. Evaluation of wound healing, anti-microbial and antioxidant potential of Pongamia pinnata in wistar rats. J. Tradit. Complement. Med. 2017, 7, 79–85. [Google Scholar] [CrossRef]
- Fahimi, S.; Abdollahi, M.; Mortazavi, S.A.; Hajimehdipoor, H.; Hajimehdipoor, H.; Abdolghaffari, A.H.; Rezvanfar, M.A. Wound healing activity of a traditionally used poly herbal product in a burn wound model in rats. Iran. Red Crescent Med. J. 2015, 17, 19960. [Google Scholar] [CrossRef]
- Akhoondinasab, M.R.; Khodarahmi, A.; Akhoondinasab, M.; Saberi, M.; Iranpour, M. Assessing effect of three herbal medicines in second and third degree burns in rats and comparison with silver sulfadiazine ointment. Burns 2015, 41, 125–131. [Google Scholar] [CrossRef]
- Kazi, M.; Al-Swairi, M.; Ahmad, A.; Raish, M.; Alanazi, F.K.; Badran, M.M.; Khan, A.A.; Alanazi, A.M.; Hussain, M.D. Evaluation of self-nanoemulsifying drug delivery systems (SNEDDS) for poorly water-soluble talinolol: Preparation, in vitro and in vivo assessment. Front. Pharmacol. 2019, 10, 459. [Google Scholar] [CrossRef]
- Izham, M.N.M.; Hussin, Y.; Aziz, M.N.M.; Yeap, S.K.; Rahman, H.S.; Masarudin, M.J.; Mohamad, N.E.; Abdullah, R.; Alitheen, N.B. Preparation and characterization of self nano-emulsifying drug delivery system loaded with citraland its antiproliferative effect on colorectal cells in vitro. Nanomaterials 2019, 9, 1028. [Google Scholar] [CrossRef] [PubMed]
- Kanwal, T.; Saifullah, S.; ur Rehman, J.; Kawish, M.; Razzak, A.; Maharjan, R.; Imran, M.; Ali, I.; Roome, T.; Simjee, S.U.; et al. Design of absorption enhancer containing self-nanoemulsifying drug delivery system (SNEDDS) for curcumin improved anti-cancer activity and oral bioavailability. J. Mol. Liq. 2021, 324, 114774. [Google Scholar] [CrossRef]
- Cherniakov, I.; Domb, A.J.; Hoffman, A. Self-nano-emulsifying drug delivery systems: An update of the biopharmaceutical aspects. Expert Opin. Drug Deliv. 2015, 12, 1121–1133. [Google Scholar] [CrossRef] [PubMed]
- Akiladevi, D.; Prakash, H.; Biju, G.; Madumitha, N. Nano-novel approach: Self nano emulsifying drug delivery system (SNEDDS)-Review article. Res. J. Pharm. Technol. 2020, 13, 983–990. [Google Scholar] [CrossRef]
- Kazi, M.; Al-Qarni, H.; Alanazi, F.K. Development of oral solid self-emulsifying lipid formulations of risperidone with improved in vitro dissolution and digestion. Eur. J. Pharm. Biopharm. 2017, 114, 239–249. [Google Scholar] [CrossRef] [PubMed]
- Senapati, P.C.; Sahoo, S.K.; Sahu, A.N. Mixed surfactant based (SNEDDS) self-nanoemulsifying drug delivery system presenting efavirenz for enhancement of oral bioavailability. Biomed. Pharmacother. 2016, 80, 42–51. [Google Scholar] [CrossRef] [PubMed]
- Bilbao-Sainz, C.; Sen Chiou, B.; Du, W.X.; Gregorsky, K.S.; Orts, W.J. Influence of disperse phase characteristics on stability, physical and antimicrobial properties of emulsions containing cinnamaldehyde. JAOCS J. Am. Oil Chem. Soc. 2013, 90, 233–241. [Google Scholar] [CrossRef]
- Puca, V.; Marulli, R.Z.; Grande, R.; Vitale, I.; Niro, A.; Molinaro, G.; Prezioso, S.; Muraro, R.; Di Giovanni, P. Microbial species isolated from infected wounds and antimicrobial resistance analysis: Data emerging from a three-years retrospective study. Antibiotics 2021, 10, 1162. [Google Scholar] [CrossRef]
- Bowler, P.G.; Duerden, B.I.; Armstrong, D.G. Wound microbiology and associated approaches to wound management. Clin. Microbiol. Rev. 2001, 14, 244–269. [Google Scholar] [CrossRef]
- Doyle, A.A.; Stephens, J.C. A review of cinnamaldehyde and its derivatives as antibacterial agents. Fitoterapia 2019, 139, 104405. [Google Scholar] [CrossRef]
- Van Liefferinge, E.; Forte, C.; Degroote, J.; Ovyn, A.; Van Noten, N.; Mangelinckx, S.; Michiels, J. In vitro and in vivo antimicrobial activity of cinnamaldehyde and derivatives towards the intestinal bacteria of the weaned piglet. Ital. J. Anim. Sci. 2022, 21, 493–506. [Google Scholar] [CrossRef]
- He, Z.; Huang, Z.; Jiang, W.; Zhou, W. Antimicrobial Activity of Cinnamaldehyde on Streptococcus mutans Biofilms. Front. Microbiol. 2019, 10, 2241. [Google Scholar] [CrossRef] [PubMed]
- Cox, H.J.; Li, J.; Saini, P.; Paterson, J.R.; Sharples, G.J.; Badyal, J.P.S. Bioinspired and eco-friendly high efficacy cinnamaldehyde antibacterial surfaces. J. Mater. Chem. B 2021, 9, 2918–2930. [Google Scholar] [CrossRef]
- Mousavi, F.; Bojko, B.; Bessonneau, V.; Pawliszyn, J. Cinnamaldehyde Characterization as an Antibacterial Agent toward E. coli Metabolic Profile Using 96-Blade Solid-Phase Microextraction Coupled to Liquid Chromatography-Mass Spectrometry. J. Proteome Res. 2016, 15, 963–975. [Google Scholar] [CrossRef] [PubMed]
- Firmino, D.F.; Cavalcante, T.T.A.; Gomes, G.A.; Firmino, N.C.S.; Rosa, L.D.; De Carvalho, M.G.; Catunda, F.E.A. Antibacterial and Antibiofilm Activities of Cinnamomum Sp. Essential Oil and Cinnamaldehyde: Antimicrobial Activities. Sci. World J. 2018, 2018, 5736. [Google Scholar] [CrossRef] [PubMed]
- Gill, A.O.; Holley, R.A. Mechanisms of bactericidal action of cinnamaldehyde against Listeria monocytogenes and of eugenol against L. monocytogenes and Lactobacillus sakei. Appl. Environ. Microbiol. 2004, 70, 5750–5755. [Google Scholar] [CrossRef]
- Sharma, U.K.; Sharma, A.K.; Gupta, A.; Kumar, R.; Pandey, A.; Pandey, A.K. Pharmacological activities of cinnamaldehyde and eugenol: Antioxidant, cytotoxic and anti-leishmanial studies. Cell. Mol. Biol. 2017, 63, 73–78. [Google Scholar] [CrossRef]
- Joghataei, M.; Hosseini, S.F.; Arab-Tehrany, E. Cinnamaldehyde loaded chitosan/tripolyphosphate nanoassemblies: Fabrication, characterization, and in vitro evaluation of antioxidant activity. J. Food Process. Preserv. 2019, 43, e13972. [Google Scholar] [CrossRef]
- Sanapalli, B.K.R.; Yele, V.; Singh, M.K.; Thaggikuppe Krishnamurthy, P.; Karri, V.V.S.R. Preclinical models of diabetic wound healing: A critical review. Biomed. Pharmacother. 2021, 142, 111946. [Google Scholar] [CrossRef]
- Kesarwani, A.; Nagpal, P.S.; Chhabra, H.S. Experimental animal modelling for pressure injury: A systematic review. J. Clin. Orthop. Trauma 2021, 17, 273–279. [Google Scholar] [CrossRef]
- Dunnill, C.; Patton, T.; Brennan, J.; Barrett, J.; Dryden, M.; Cooke, J.; Leaper, D.; Georgopoulos, N.T. Reactive oxygen species (ROS) and wound healing: The functional role of ROS and emerging ROS-modulating technologies for augmentation of the healing process. Int. Wound J. 2017, 14, 89–96. [Google Scholar] [CrossRef] [PubMed]
- Süntar, I.; Akkol, E.K.; Nahar, L.; Sarker, S.D. Wound healing and antioxidant properties: Do they coexist in plants? Free Rad. Antioxid. 2012, 2, 1–7. [Google Scholar] [CrossRef]
- Blass, S.C.; Goost, H.; Tolba, R.H.; Stoffel-Wagner, B.; Kabir, K.; Burger, C.; Stehle, P.; Ellinger, S. Time to wound closure in trauma patients with disorders in wound healing is shortened by supplements containing antioxidant micronutrients and glutamine: A PRCT. Clin. Nutr. 2012, 31, 469–475. [Google Scholar] [CrossRef]
- Laggner, M.; Lingitz, M.T.; Copic, D.; Direder, M.; Klas, K.; Bormann, D.; Gugerell, A.; Moser, B.; Radtke, C.; Hacker, S.; et al. Severity of thermal burn injury is associated with systemic neutrophil activation. Sci. Rep. 2022, 12, 1–10. [Google Scholar] [CrossRef] [PubMed]
- Phan, T.T.; Wang, L.; See, P.; Grayer, R.J.; Chan, S.Y.; Lee, S.T. Phenolic compounds of Chromolaena adorata protect cultured skin cells from oxidative damage: Implication for cutaneous wound healing. Biol. Pharm. Bull. 2001, 24, 1373–1379. [Google Scholar] [CrossRef] [PubMed]
- Lateef, Z.; Stuart, G.; Jones, N.; Mercer, A.; Fleming, S.; Wise, L. The cutaneous inflammatory response to thermal burn injury in a Murine model. Int. J. Mol. Sci. 2019, 20, 538. [Google Scholar] [CrossRef]
- Shallo, H.; Plackett, T.P.; Heinrich, S.A.; Kovacs, E.J. Monocyte chemoattractant protein-1 (MCP-1) and macrophage infiltration into the skin after burn injury in aged mice. Burns 2003, 29, 641–647. [Google Scholar] [CrossRef]
- Shukla, A.; Rasik, A.M.; Dhawan, B.N. Asiaticoside-induced elevation of antioxidant levels in healing wounds. Phyther. Res. 1999, 13, 50–54. [Google Scholar] [CrossRef]
- Kurahashi, T.; Fujii, J. Roles of antioxidative enzymes in wound healing. J. Dev. Biol. 2015, 3, 57–70. [Google Scholar] [CrossRef]
- Saeidnia, S.; Abdollahi, M. Toxicological and pharmacological concerns on oxidative stress and related diseases. Toxicol. Appl. Pharmacol. 2013, 273, 442–455. [Google Scholar] [CrossRef]
- Mohammadi, A.; Mohammad-Alizadeh-Charandabi, S.; Mirghafourvand, M.; Javadzadeh, Y.; Fardiazar, Z.; Effati-Daryani, F. Effects of cinnamon on perineal pain and healing of episiotomy: A randomized placebo-controlled trial. J. Integr. Med. 2014, 12, 359–366. [Google Scholar] [CrossRef]
- Chericoni, S.; Prieto, J.M.; Iacopini, P.; Cioni, P.; Morelli, I. In vitro activity of the essential oil of Cinnamomum zeylanicum and eugenol in peroxynitrite-induced oxidative processes. J. Agric. Food Chem. 2005, 53, 4762–4765. [Google Scholar] [CrossRef] [PubMed]
- Mendes, S.J.F.; Sousa, F.I.A.B.; Pereira, D.M.S.; Ferro, T.A.F.; Pereira, I.C.P.; Silva, B.L.R.; Pinheiro, A.J.; Mouchrek, A.Q.S.; Monteiro-Neto, V.; Costa, S.K.P.; et al. Cinnamaldehyde modulates LPS-induced systemic inflammatory response syndrome through TRPA1-dependent and independent mechanisms. Int. Immunopharmacol. 2016, 34, 60–70. [Google Scholar] [CrossRef]
- Kim, M.E.; Na, J.Y.; Lee, J.S. Anti-inflammatory effects of trans-cinnamaldehyde on lipopolysaccharide-stimulated macrophage activation via MAPKs pathway regulation. Immunopharmacol. Immunotoxicol. 2018, 40, 219–224. [Google Scholar] [CrossRef] [PubMed]
- Pannee, C.; Chandhanee, I.; Wacharee, L. Anti-inflammatory effects of essential oil from the leaves of Cinnamomum cassia and cinnamaldehyde on lipopolysaccharide-stimulated J774A.1 cells. J. Adv. Pharm. Technol. Res. 2014, 5, 164–170. [Google Scholar] [CrossRef] [PubMed]
- Zhang, L.; Zhang, Z.; Fu, Y.; Yang, P.; Qin, Z.; Chen, Y.; Xu, Y. Trans-cinnamaldehyde improves memory impairment by blocking microglial activation through the destabilization of iNOS mRNA in mice challenged with lipopolysaccharide. Neuropharmacology 2016, 110, 503–518. [Google Scholar] [CrossRef] [PubMed]
- Hansbrough, J.F.; Wikström, T.; Braide, M.; Tenenhaus, M.; Rennekampff, O.H.; Kiessig, V.; Bjursten, L.M. Neutrophil activation and tissue neutrophil sequestration in a rat model of thermal injury. J. Surg. Res. 1996, 61, 17–22. [Google Scholar] [CrossRef][Green Version]
- Rennekampff, O.H.; Tenenhaus, M.; Hansbrough, J.; Kiessig, V.; Zapata-Sirvent, R.L. Effects of recombinant bactericidal, permeability-increasing protein on bacterial translocation and pulmonary neutrophil sequestration in burned mice. J. Burn Care Rehabil. 1997, 18, 17–21. [Google Scholar] [CrossRef]
- Demling, R.H.; LaLonde, C. Early burn excision attenuates the postburn lung and systemic response to endotoxin. Surgery 1990, 108, 28–35. [Google Scholar] [PubMed]
- Klebanoff, S.J. Myeloperoxidase: Friend and foe. J. Leukoc. Biol. 2005, 77, 598–625. [Google Scholar] [CrossRef]
- Hansson, M.; Olsson, I.; Nauseef, W.M. Biosynthesis, processing, and sorting of human myeloperoxidase. Arch. Biochem. Biophys. 2006, 445, 214–224. [Google Scholar] [CrossRef] [PubMed]
- Anderson, B.O.; Brown, J.M.; Harken, A.H. Mechanisms of neutrophil-mediated tissue injury. J. Surg. Res. 1991, 51, 170–179. [Google Scholar] [CrossRef]
- Hansbrough, J.F.; Wikström, T.; Braide, M.; Tenenhaus, M.; Rennekampff, O.H.; Kiessig, V.; Zapata-Sirvent, R.; Bjursten, L.M. Effects of E-selectin and P-selectin blockade on neutrophil sequestration in tissues and neutrophil oxidative burst in burned rats. Crit. Care Med. 1996, 24, 1366–1372. [Google Scholar] [CrossRef]
- Mulligan, M.S.; Till, G.O.; Smith, C.W.; Anderson, D.C.; Miyasaka, M.; Tamatani, T.; Todd, R.F.; Issekutz, T.B.; Ward, P.A. Role of leukocyte adhesion molecules in lung and dermal vascular injury after thermal trauma of skin. Am. J. Pathol. 1994, 144, 1008–1015. [Google Scholar] [PubMed]
- Mohammed, H.A.; Sulaiman, G.M.; Anwar, S.S.; Tawfeeq, A.T.; Khan, R.A.; Mohammed, S.A.A.; Al-Omar, M.S.; Alsharidah, M.; Al Rugaie, O.; Al-Amiery, A.A. Quercetin against MCF7 and CAL51 breast cancer cell lines: Apoptosis, gene expression and cytotoxicity of nano-quercetin. Nanomedicine 2021, 16, 1937–1961. [Google Scholar] [CrossRef] [PubMed]
- Qureshi, K.A.; Imtiaz, M.; Parvez, A.; Rai, P.K.; Jaremko, M.; Emwas, A.H.; Bholay, A.D.; Fatmi, M.Q. In Vitro and In Silico Approaches for the Evaluation of Antimicrobial Activity, Time-Kill Kinetics, and Anti-Biofilm Potential of Thymoquinone (2-Methyl-5-propan-2-ylcyclohexa-2, 5-diene-1,4-dione) against Selected Human Pathogens. Antibiotics 2022, 11, 79. [Google Scholar] [CrossRef]
- Qureshi, K.A.; Bholay, A.D.; Rai, P.K.; Mohammed, H.A.; Khan, R.A.; Azam, F.; Jaremko, M.; Emwas, A.H.; Stefanowicz, P.; Waliczek, M.; et al. Isolation, characterization, anti-MRSA evaluation, and in-silico multi-target anti-microbial validations of actinomycin X2 and actinomycin D produced by novel Streptomyces smyrnaeus UKAQ_23. Sci. Rep. 2021, 11, 1–21. [Google Scholar] [CrossRef]
- Mohammed, H.A.; Ali, H.M.; Qureshi, K.A.; Alsharidah, M.; Kandil, Y.I.; Said, R.; Mohammed, S.A.A.; Al-omar, M.S.; Al Rugaie, O.; Abdellatif, A.A.H.; et al. Comparative Phytochemical Profile and Biological Activity of Four Major Medicinal Halophytes from Qassim Flora. Plants 2021, 10, 2208. [Google Scholar] [CrossRef]
- Elshikh, M.; Ahmed, S.; Funston, S.; Dunlop, P.; McGaw, M.; Marchant, R.; Banat, I.M. Resazurin-based 96-well plate microdilution method for the determination of minimum inhibitory concentration of biosurfactants. Biotechnol. Lett. 2016, 38, 1015–1019. [Google Scholar] [CrossRef]
- Mohammed, H.A.; Qureshi, K.A.; Ali, H.M.; Al-omar, M.S.; Khan, O.; Mohammed, S.A.A. Bio-Evaluation of the Wound Healing Activity of Artemisia judaica L. as Part of the Plant’s Use in Traditional Medicine; Phytochemical, Antioxidant, Anti-Inflammatory, and Antibiofilm Properties of the Plant’s Essential Oils. Antioxidants 2022, 11, 332. [Google Scholar] [CrossRef]
- Aroua, L.M.; Almuhaylan, H.R.; Alminderej, F.M.; Messaoudi, S.; Chigurupati, S.; Al-mahmoud, S.; Hamdoon, M.H. A facile approach synthesis of benzoylaryl benzimidazole as potential α-amylase and α-glucosidase inhibitor with antioxidant activity. Bioorg. Chem. 2021, 114, 105073. [Google Scholar] [CrossRef] [PubMed]
- Mohammed, H.A.A.; Al-Omar, M.S.; Khan, R.A.; Mohammed, S.A.A.; Qureshi, K.A.; Abbas, M.M.; Al Rugaie, O.; Abd-Elmoniem, E.; Ahmad, A.M.; Kandil, Y.I. Chemical profile, antioxidant, antimicrobial, and anti-cancer activities of the water-ethanol extract of pulicaria undulata growing in the oasis of central saudi arabian desert. Plants 2021, 10, 1811. [Google Scholar] [CrossRef] [PubMed]
- Kirkwood, B.R.; Sterne, J.A.C. Essential Medical Statistics; Essentials; Wiley: Hoboken, NJ, USA, 2003; ISBN 978-0-86542-871-3. [Google Scholar]

| Microorganisms | IZD (Mean ± SD) | |||
|---|---|---|---|---|
| CA-SNEDDS | SNEDDS | Positive Control | Negative Control | |
| Gram-Positive Bacteria | ||||
| Staphylococcus aureus (S. aureus) ATCC 29213 | 15.0 ± 0.2 | 6.0 ± 0.0 | 19.0 ± 0.3 | 6.0 ± 0.0 |
| Methicillin-resistantS. aureus (MRSA) * | 17.0 ± 0.3 | 6.0 ± 0.0 | 21.0 ± 0.2 | 6.0 ± 0.0 |
| Staphylococcus aureus (S. saptophyticus) ATCC 43867 | 8.0 ± 0.9 | 6.0 ± 0.0 | 10.0 ± 0.3 | 6.0 ± 0.0 |
| Bacillus cereus (B. cereus) ATCC 10876 | 8.0 ± 0.5 | 6.0 ± 0.0 | 10.0 ± 0.2 | 6.0 ± 0.0 |
| Gram-Negative Bacteria | ||||
| Escherichia coli (E. coli) ATCC 25922 | 13.0 ± 0.5 | 6.0 ± 0.0 | 15.0 ± 0.1 | 6.0 ± 0.0 |
| Klebsiella pneumoniae (K. pneumoniae) ATCC 27736 | 11.0 ± 0.5 | 6.0 ± 0.0 | 12.0 ± 0.3 | 6.0 ± 0.0 |
| Pseudomonas aeruginosa (P. aeruginosa) ATCC 9027 | 8.0 ± 0.5 | 6.0 ± 0.0 | 10.0 ± 0.3 | 6.0 ± 0.0 |
| Salmonella typhimurium (S. typhimurium) ATCC 13311 | 19.0 ± 0.9 | 6.0 ± 0.0 | 21.0 ± 0.3 | 6.0 ± 0.0 |
| Fungal Strains | ||||
| Candida albicans (C. albicans) ATCC 10231 | 35.0 ± 0.5 | 6.0 ± 0.0 | 40.0 ± 0.1 | 6.0 ± 0.0 |
| Aspergillus niger (A. niger) ATCC 6275 | 34.0 ± 0.5 | 6.0 ± 0.0 | 42.0 ± 0.4 | 6.0 ± 0.0 |
| Microorganisms | MIC | MBC | MBIC | MBEC |
|---|---|---|---|---|
| Gram-Positive Bacteria | ||||
| S. aureus ATCC 29213 | 6.25 | 12.5 | 12.5 | 25 |
| MRSA | 3.125 | 6.25 | 6.25 | 12.5 |
| S. saptophyticus ATCC 43867 | 3.125 | 6.25 | 6.25 | 12.5 |
| B. cereus ATCC 10876 | 6.25 | 12.5 | 12.5 | 25 |
| Gram-Negative Bacteria | ||||
| E. coli ATCC 25922 | 3.125 | 6.25 | 6.25 | 12.5 |
| K. pneumoniae ATCC 27736 | 3.125 | 6.25 | 6.25 | 12.5 |
| P. aeruginosa ATCC 9027 | 3.125 | 6.25 | 6.25 | 12.5 |
| S. typhimurium ATCC 13311 | 3.125 | 6.25 | 6.25 | 12.5 |
| Fungal Strains | ||||
| C. albicans ATCC 10231 | 1.56 | 3.125 | 3.125 | 6.25 |
| A. niger ATCC 6275 | 1.56 | 3.125 | 3.125 | 6.25 |
| Compounds | TAC | DPPH-SA |
|---|---|---|
| CA | 18.16 ± 0.84 | 6.60 ± 0.03 |
| CA-SNEDDS | 17.21 ± 0.72 | 6.57 ± 0.05 |
Publisher’s Note: MDPI stays neutral with regard to jurisdictional claims in published maps and institutional affiliations. |
© 2022 by the authors. Licensee MDPI, Basel, Switzerland. This article is an open access article distributed under the terms and conditions of the Creative Commons Attribution (CC BY) license (https://creativecommons.org/licenses/by/4.0/).
Share and Cite
Qureshi, K.A.; Mohammed, S.A.A.; Khan, O.; Ali, H.M.; El-Readi, M.Z.; Mohammed, H.A. Cinnamaldehyde-Based Self-Nanoemulsion (CA-SNEDDS) Accelerates Wound Healing and Exerts Antimicrobial, Antioxidant, and Anti-Inflammatory Effects in Rats’ Skin Burn Model. Molecules 2022, 27, 5225. https://doi.org/10.3390/molecules27165225
Qureshi KA, Mohammed SAA, Khan O, Ali HM, El-Readi MZ, Mohammed HA. Cinnamaldehyde-Based Self-Nanoemulsion (CA-SNEDDS) Accelerates Wound Healing and Exerts Antimicrobial, Antioxidant, and Anti-Inflammatory Effects in Rats’ Skin Burn Model. Molecules. 2022; 27(16):5225. https://doi.org/10.3390/molecules27165225
Chicago/Turabian StyleQureshi, Kamal A., Salman A. A. Mohammed, Omar Khan, Hussein M. Ali, Mahmoud Z. El-Readi, and Hamdoon A. Mohammed. 2022. "Cinnamaldehyde-Based Self-Nanoemulsion (CA-SNEDDS) Accelerates Wound Healing and Exerts Antimicrobial, Antioxidant, and Anti-Inflammatory Effects in Rats’ Skin Burn Model" Molecules 27, no. 16: 5225. https://doi.org/10.3390/molecules27165225
APA StyleQureshi, K. A., Mohammed, S. A. A., Khan, O., Ali, H. M., El-Readi, M. Z., & Mohammed, H. A. (2022). Cinnamaldehyde-Based Self-Nanoemulsion (CA-SNEDDS) Accelerates Wound Healing and Exerts Antimicrobial, Antioxidant, and Anti-Inflammatory Effects in Rats’ Skin Burn Model. Molecules, 27(16), 5225. https://doi.org/10.3390/molecules27165225

